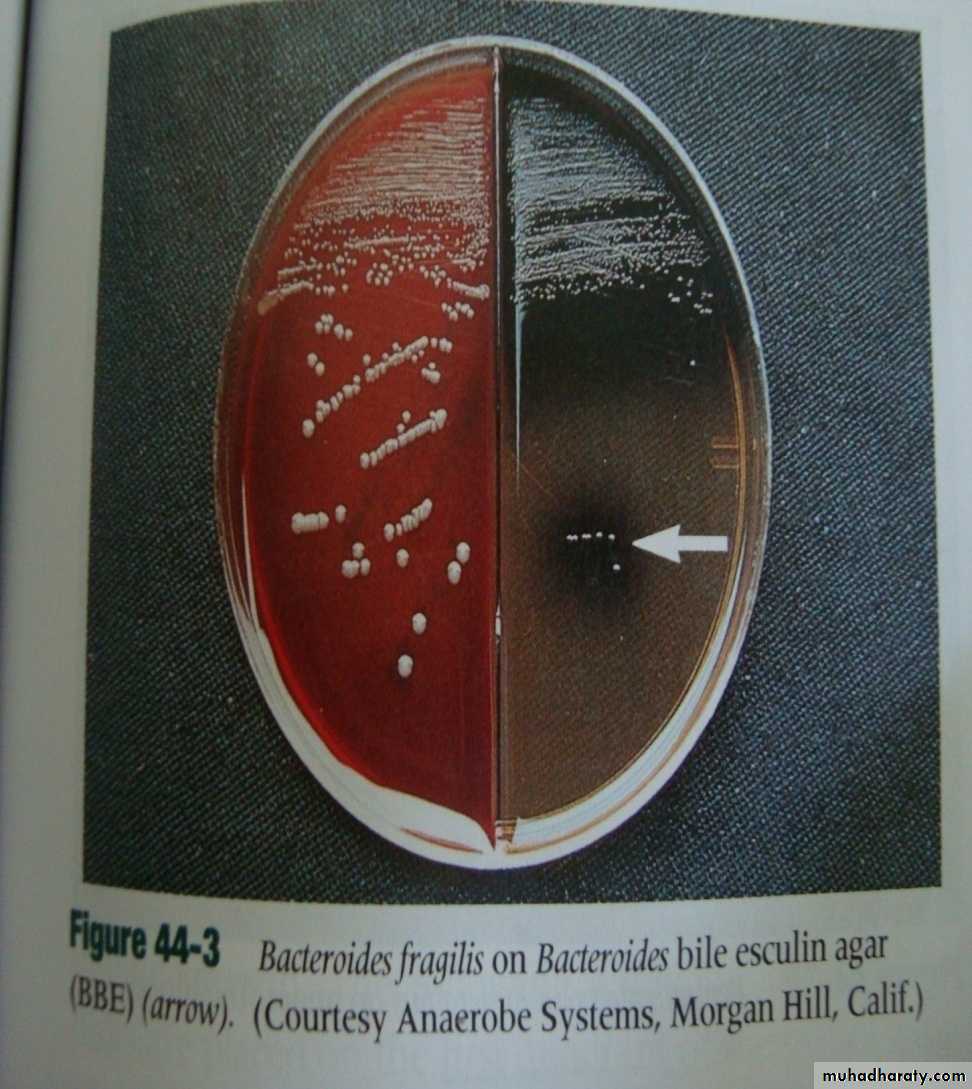
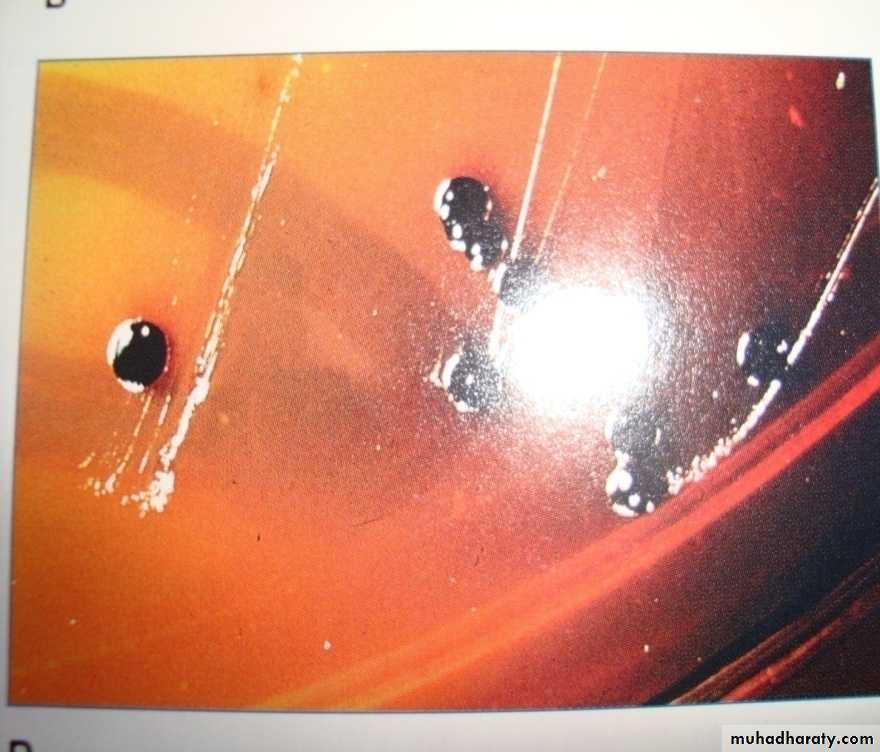
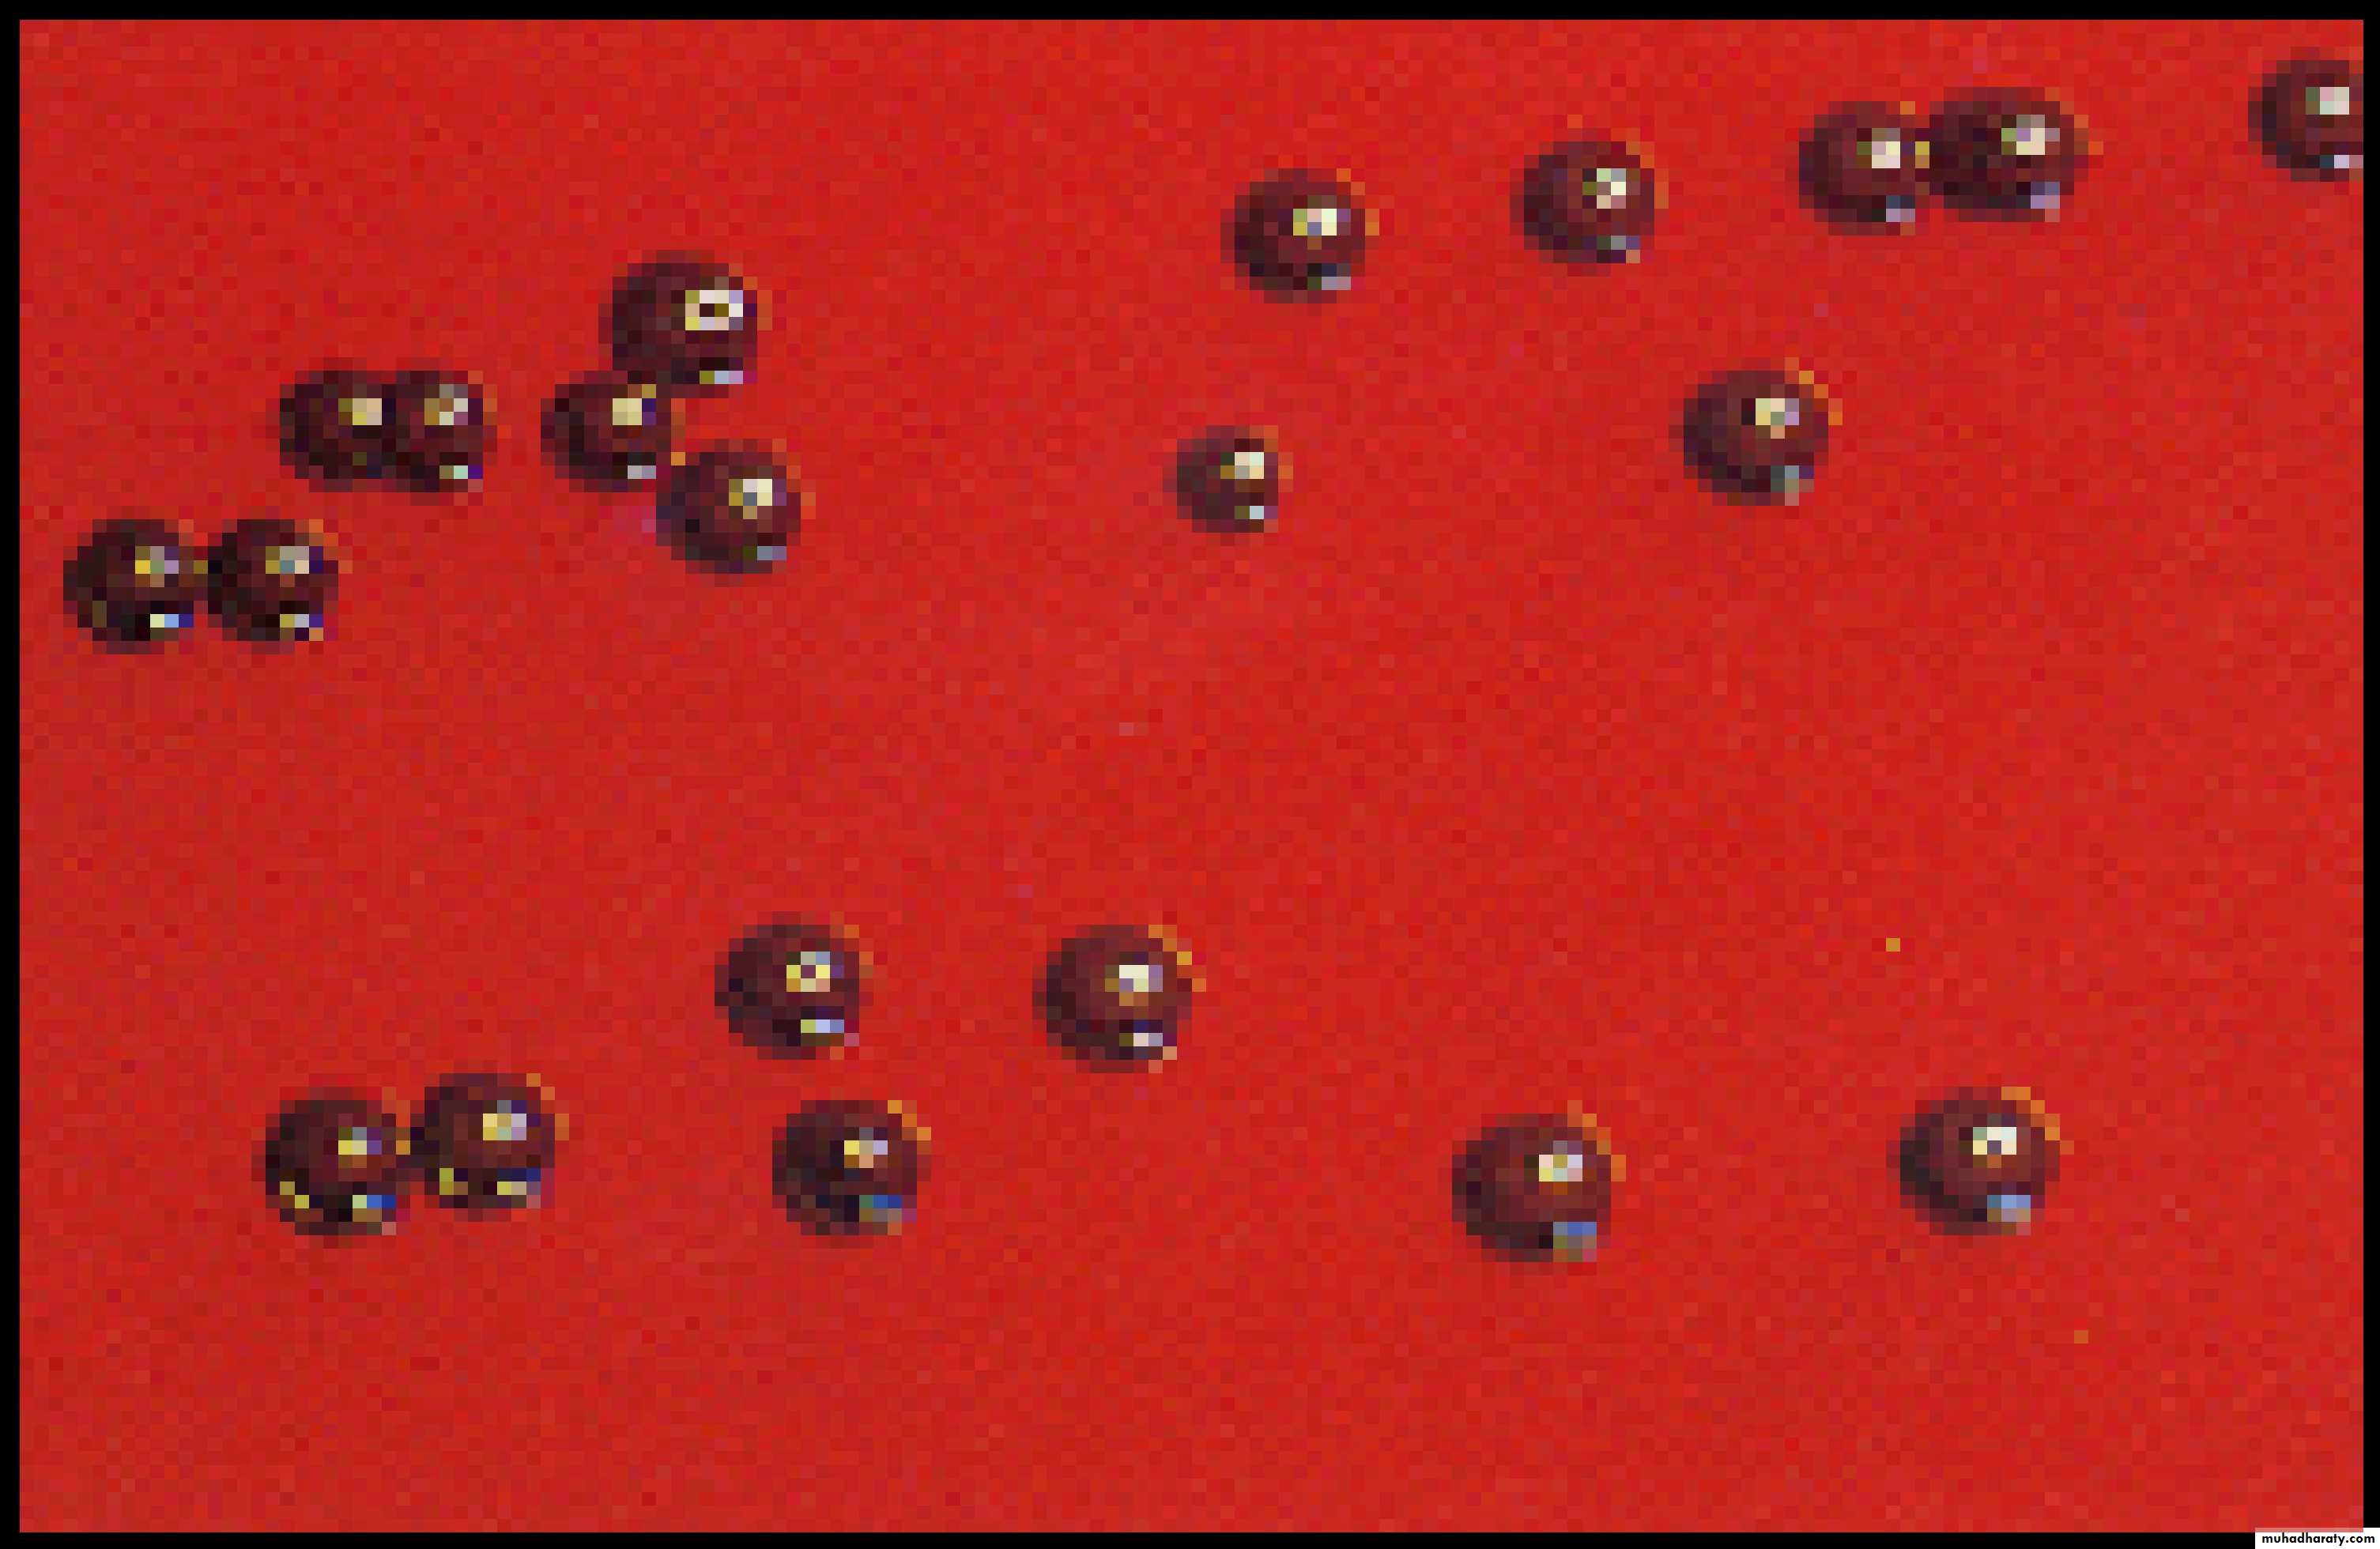

Fusobacteria & Leptotrichia
FusobacteriaFusobacterium nucleatum
Habitat and transmission
Several subspecies of F. nucleatum have been dentified in different habitats.
These include:
1- F. nucleatum subsp. polymorphum,found in the healthy gingival crevice, and
2- F. Nucleatum subsp. nucleatum,
recovered mainly from periodonta pockets.3- A third subspecies is F. nucleatum subsp. vincentii.
Infections are almost invariably endogenous..
A photomicrograph of fusobacteria showing characteristic
Gram-negative, cigar-shaped cells with pointed ends.
• Characteristics
• Gram-negative, strictly anaerobic, cigar-shaped bacilli with pointed ends ( Cells often have a central swelling.• A Gram-stained smear of deep gingival debris obtained from a lesion of acute ulcerative gingivitis is a
• These, together with the clinical picture, confirm a clinical diagnosis of acute ulcerative gingivitis
The endotoxin of the organism appears to be involved in the pathogenesis of periodontal disea
1- adherence properties
2- F. nucleatum is usually isolated from polymicrobial infectionsThus, in combination with oral spirochaetes it causes the classic fusospirochaetal I nfections.
These are:
•
acute (necrotizing) ulcerative gingivitis or trench mouth (Vincent’s angina, an ulcerative tonsillitis causing tissue necrosis, often due to extension of acute ulcerative gingivitis
As fusobacteria coaggregate with most other oral bacteria, bridging organisms between early and late colonizers during plaque formation
A Gram-stained smear obtained from deep gingival plaque of a
patient with acute ulcerative gingivitis showing the fusospirochaetal complex. Note: the large cells are polymorphs.Antibiotic sensitivity and prevention
Fusobacteria are uniformly sensitive to penicillin and, being strict anaerobes, are sensitive to metronidazole.Regular oral hygiene and antiseptic mouthwashes are the key to prevention
of oral fusobacterial infections in susceptible
individuals.
Leptotrichia spp
. are oral commensals previously thought to belong to the genus Fusobacterium. They are Gram-negative, strictly anaerobic, slender, filamentous bacilli, usually with one pointed end.Leptotrichia buccalis, present in low proportions in dental plaque, is the sole representative of this genus
Thank you
Anaerobic BacteriaBacteroides, Porphyromonas
and Prevotella
Bacteroides spp. are mainly restricted to species found
predominantly in the gut and are the most commonagents of serious anaerobic infections;
Bacteroides fragilis is the main pathogen.
Porphyromonas spp. are a saccharolytic pigmented species
and form part of the normal oral flora. They are agents
of periodontal disease and hence considered as
periodontopathic organisms.
• Prevotella spp. include saccharolytic oral and genitourinary species; some species are periodontopathic.
Collectively, Tannerella, Porphyromonas and Prevotella species are referred to as black-pigmented anaerobes, as some organisms from these genera form a characteristic brown or black pigment on blood agar
Habitat and transmission
Bacteroides species are the most predominant flora in the intestine (1011 cells per gram of faecesThey cause serious anaerobic infections such
as intra-abdominal sepsis, peritonitis, liver and brain abscesses, and wound infection.
Characteristics
Strictly anaerobic, Gram-negative, non-motile, non-sporing bacilli, but may appearpleomorphic.
The polysaccharide capsule is an important virulence factor.
Pathogenicity
Mainly the result of its endotoxin and proteases. No exotoxin has been reported.Other organisms, such as coliforms, are commonly associated with sepsis.
The latter facultative anaerobes utilize oxygen in the infective focus and facilitate the growth of the anaerobic Bacteroides strains.
Consequently, many Bacteroides infections are polymicrobial in nature.
Bacteroides fragilisPorphyromonasPorphyromonas gingivalis
Habitat and transmissionFound almost solely at subgingival sites, particularly in advanced periodontal disease: considered a consensus periodontal pathogen.
The three members are:
Porphyromonas gingivalisTannerella forsythia
Treponema denticola
are considered the three agents of ‘red complex’ bacteria almost always associated with periodontal disease
P. gingivalis is sometimes recovered from the tongue and tonsils.
Characteristics
Non-motile asaccharolytic, short, pleomorphic, Gram negative coccobacilli.
Pathogenicity
An aggressive periodontal pathogen in both humans and animals (e.g. guinea pig, monkey, beagle dogs);its fimbriae mediate adhesion and the capsule defends against phagocytosis.
Produces a range of virulence factors including
collagenase, endotoxin, fibrinolysin, phospholipase many proteases that destroy immunoglobulins, a fibroblast-inhibitory factor, complement.Prevotella
This genus includes a number of pigmented as well as nonpigmented species that are moderately saccharolytic; all produce acetic and succinic acid from glucose.Prevotella melaninogenica are coccobacilli that are commonly found in the oral cavity of humans;.
Prevotella spp.
Habitat and transmissionThe predominant ecological niche of all Prevotella species appears to be the human oral cavity.
Strains of Prevotella intermedia are associated more with periodontal disease,
Prevotella nigrescens is isolated more often from healthy gingival sites
• Pathogenicity
P. intermedia is closely associated with periodontal diseaseand shares a number of virulence properties exhibited by P.
gingivalis.
These organisms are classified as belonging to the
‘orange complex’ bacteria associated with the developmentalstages of periodontal disease, and precedes the arrival of the
‘red complex’ group of bacteria
The pathogenicity of other subdivided species non-pigmented species such as
Prevotella buccae,Prevotella oralis
Prevotella dentalis
are isolated on occasion from healthy subgingival plaque and increased its proportions during periodontal
• Legionella pneumophila
Habitat and transmissionThe organism found in soil and water, including air conditioning units, domestic and hospital water supplies, and sometimes in dental unit water systems.
Spread is known to occur by contaminated aerosols.
.